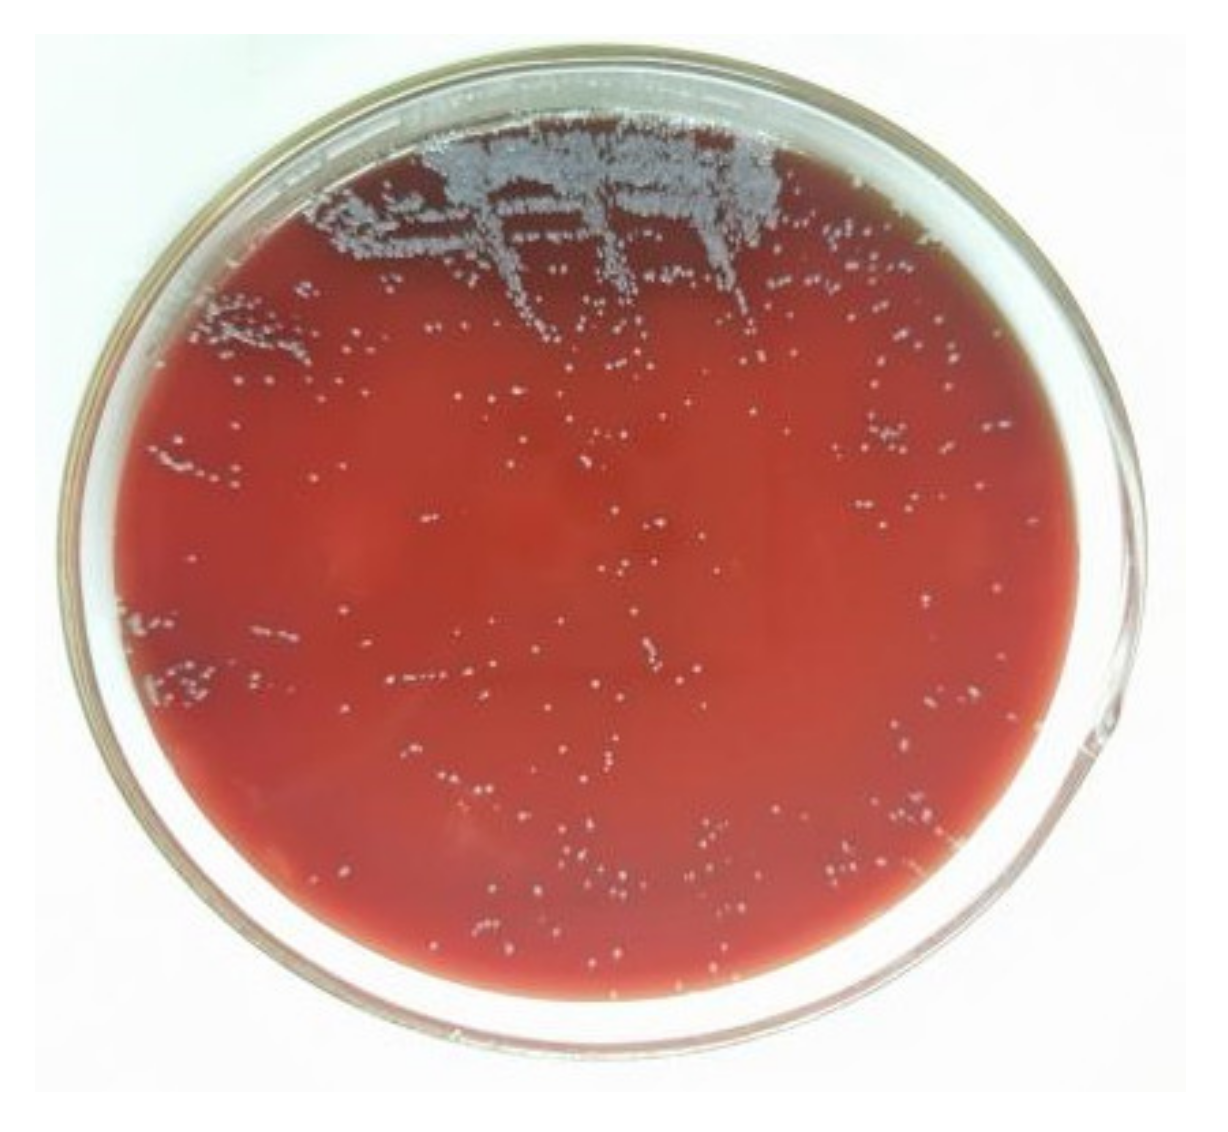
Vetsci 09 00653 g001
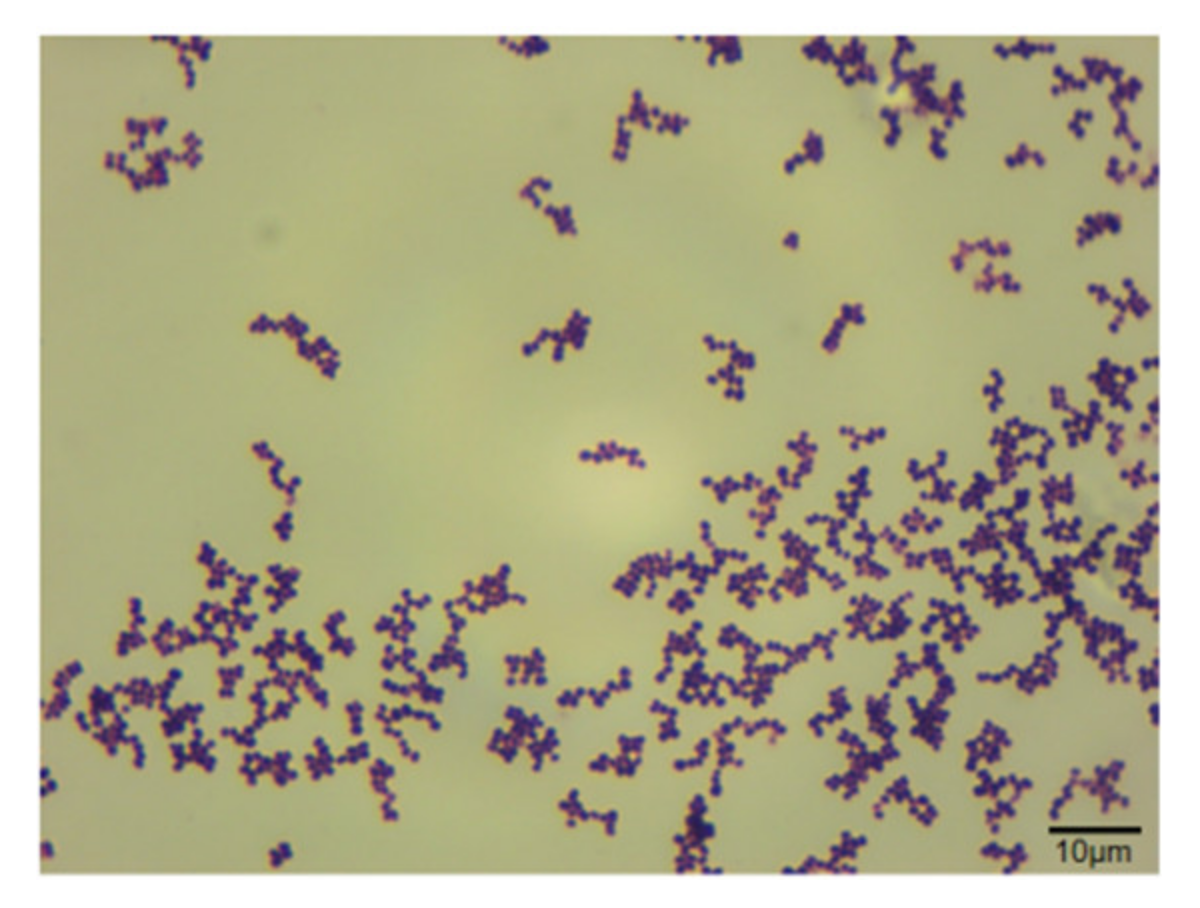
Vetsci 09 00653 g002

Rothia nasimurium as a Cause of Disease: First Isolation from Farmed Chickens
Abstract
Simple Summary
Abstract
1. Introduction
2. Materials and Methods
2.1. Isolation and Purification
2.2. Virus Detection
2.3. Bacterial Identification
2.3.1. Observation of Gram Staining
2.3.2. Bacterial Biochemical Test
2.3.3. Matrix-Assisted Laser Desorption/Ionization Time-of-Flight Mass Spectrometry (MALDI-TOF MS)
2.4. Sequence Analysis of 16S rRNA
2.5. Antibiotic Susceptibility Testing
2.6. Detection of Antibiotic Resistance Genes
2.7. Animal Pathogenicity Test
3. Results
3.1. Virus Detection Results
3.2. Isolation and Purification
3.3. Animal Regression Experiment
3.3.1. Gram Staining
3.3.2. Bacterial Biochemical Test
3.3.3. MALDI-TOF MS Identification
3.4. Alignment of Bacterial 16S rRNA Sequences and Construction of Phylogenetic Tree
3.5. Antibiotic Susceptibility Testing
3.6. Detection of Antibiotic Resistance Genes
3.7. Animal Pathogenicity Experiment
4. Discussion
5. Conclusions
Supplementary Materials
Author Contributions
Funding
Institutional Review Board Statement
Informed Consent Statement
Data Availability Statement
Acknowledgments
Conflicts of Interest
References
- Collins, M.D.; Hutson, R.; Baverud, V.; Falsen, E. Characterization of a Rothia-like organism from a mouse: Description of Rothia nasimurium sp. nov. and reclassification of Stomatococcus mucilaginosus as Rothia mucilaginosa comb. nov. Int. J. Syst. Evol. Microbiol. 2000, 50, 1247–1251. [Google Scholar] [CrossRef] [PubMed]
- Li, N. Distribution and Resistance of Airborne Bacteria in Farms. Ph.D. Thesis, PLA Academy of Military Medical Sciences, Beijing, China, 2011. [Google Scholar]
- Bemis, D.A.; Bryant, M.J.; Reed, P.P.; Brahmbhatt, R.A.; Kania, S.A. Synergistic hemolysis between β-lysin-producing Staphylococcus species and Rothia nasimurium in primary cultures of clinical specimens obtained from dogs. J. Vet. Diagn. Investig. 2014, 26, 437–441. [Google Scholar] [CrossRef] [PubMed]
- Hansen, C.M.; Meixell, B.W.; Van Hemert, C.; Hare, R.F.; Hueffer, K. Microbial Infections Are Associated with Embryo Mortality in Arctic-Nesting Geese. Appl. Environ. Microbiol. 2015, 81, 5583–5592. [Google Scholar] [CrossRef] [PubMed][Green Version]
- Gaiser, R.A.; Medema, M.H.; Kleerebezem, M.; van Baarlen, P.; Wells, J.M. Draft Genome Sequence of a Porcine Commensal, Rothia nasimurium, Encoding a Nonribosomal Peptide Synthetase Predicted To Produce the Ionophore Antibiotic Valinomycin. Genome Announc. 2017, 5, e00453-17. [Google Scholar] [CrossRef] [PubMed]
- Wang, M.; Li, Y.; Lin, X.; Xu, H.; Li, Y.; Xue, R.; Wang, G.; Sun, S.; Li, J.; Lan, Z.; et al. Genetic characterization, mechanisms and dissemination risk of antibiotic resistance of multidrug-resistant Rothia nasimurium. Infect. Genet. Evol. 2021, 90, 104770. [Google Scholar] [CrossRef] [PubMed]
- Zhao, Q.Y. A case report of Rothia nasimurium infection in rabbit. Chin. J. Rabbit. Farming 2021, 2, 36–37. (In Chinese) [Google Scholar]
- Kang, Y.H.; Zhou, H.S.; Jin, W.J. Rothia nasimurium as a Cause of Disease: First Isolation from Farmed Geese. Vet. Sci. 2022, 9, 197. [Google Scholar] [CrossRef]
- Bolhuis, H.; van Veen, H.W.; Brands, J.R.; Putman, M.; Poolman, B.; Driessen, A.J.; N, W. Konings Energetics and mechanism of drug transport mediated by the lactococcal multidrug transporter LmrP. Biol. Chem. 1996, 271, 24123–24128. [Google Scholar] [CrossRef]
- Steinfels, E.; Orelle, C.; Fantino, J.; Dalmas, O.; Rigaud, J.; Denizot, F.; di Pietro, A.; Jault, J. Characterization of YvcC(BmrA), a multidrug ABC transporter constitutively expressed in Bacillus subtilis. Biochemistry 2004, 43, 7491–7502. [Google Scholar] [CrossRef]
- Dong, Z.; Zhou, X.Z.; Sun, J.C.; Meng, X.B.; Li, H.S.; Cheng, F.S.; Wei, X.J.; Li, B.; Wang, W.W.; Zhang, J.Y. Efficacy of enteric-coated tilmicosin granules in pigs artificially infected with Actinobacillus pleuropneumoniae serotype 2. Vet. Med. Sci. 2020, 6, 105–113. [Google Scholar] [CrossRef]
- Dao, H.T.; Do, V.T.; Truong, Q.L.; Hahn, T.W. Enhancement of Apx Toxin Production in Actinobacillus pleuropneumoniae Serotypes 1, 2, and 5 by Optimizing Culture Condition. J. Microbiol. Biotechnol. 2020, 30, 1037–1043. [Google Scholar] [CrossRef]
- Molter, C.; Escobar, A.; Schroeder, C. Backyard Poultry and Waterfowl Sedation and Anesthesia. Vet. Clin. N. Am. Exot. Anim. Pract. 2021, 25, 163–180. [Google Scholar] [CrossRef]
- Peng, J.C. Pathogenic, Drug Resistance and Diagnostic Characteristics of Traumatic Osteomyelitis. Ph.D. Thesis, Suzhou University, Suzhou, China, 2018. [Google Scholar]
- Pang, F. Analysis of Antibiotic and Clinical Infection Characteristics of IMP Metalloenzyme Producing Enterobacteriaceae. Ph.D. Thesis, Shandong University, Jinan, China, 2018. [Google Scholar]
- Lynch, K.D.; Brian, G.; Ahwang, T.; Newie, T.; Newie, V.; Perrett, C.; Wharton, G.; Brown, A.; Tozer, S.; Kaldor, J.M.; et al. Discord between presence of follicular conjunctivitis and Chlamydia trachomatis infection in a single Torres Strait Island community: A cross-sectional survey. Aust. N. Z. J. Public Health 2022, 16, 16. [Google Scholar] [CrossRef]
- Huang, P. Antimicrobial Susceptibility, and Molecular Characterization of Staphylococcus aureus Isolated from Raw Milk in China. Ph.D. Thesis, Chinese Academy of Agricultural Sciences, Beijing, China, 2018. [Google Scholar]
- Abu, D.; Abula, T.; Zewdu, T.; Berhanu, M.; Sahilu, T. Asymptomatic Bacteriuria, antimicrobial susceptibility pattern and associated risk factors among pregnant women attending antenatal care in Assosa General Hospital, Western Ethiopia. BMC Microbiol. 2021, 21, 348. [Google Scholar] [CrossRef]
- Bergey, D.H. Bergey’s Manual of Determinative Bacteriology. Eighth Edition. Am. J. Public Health 1975, 65, 315. [Google Scholar]
- Cheng, W.; Shi, H.; Teng, M.; Yu, M.; Feng, B.; Ding, C.; Yu, S.; Yang, F. Rapid identification of bacterial mixtures in urine using MALDI-TOF MS-based algorithm profiling coupled with magnetic enrichment. Analyst 2021, 147, 443–449. [Google Scholar] [CrossRef]
- Bianey, G.L.; Katarzyna, W.; Alma, R.C.E.; Oracio, S.T.; Israel, E.D.; Kazimierz, W. Mass spectrometry-based identifcation of bacteria isolated from industrially contaminated site in Salamanca (Mexico) and evaluation of their potential for DDT degradation. Folia Microbiol. 2021, 66, 355–369. [Google Scholar]
- Xu, J.; Guo, S.; Li, D.; Wang, Q.; Chen, C. Study on Anti-diarrhea Effect of the Prescription of 4 Tibetan Veterinary Drugs. Agric. Biotechnol. 2017, 6, 32–37. [Google Scholar]
- Yang, C.; Li, H.; Zhang, T.; Chu, Y.; Zuo, J.; Chen, D. Study on antibiotic susceptibility of Salmonella typhimurium L forms to the third and forth generation cephalosporins. Sci. Rep. 2020, 10, 3042. [Google Scholar] [CrossRef]
- Sarshar, S.; Mirnejad, R.; Babapour, E. Frequency of blaCTX-M and blaTEM Virulence Genes and Antibiotic Resistance Profiles among Klebsiella pneumoniae Isolates in Urinary Tract Infection (UTI) Samples from Hashtgerd, Iran. Rep. Biochem. Mol. Biol. 2021, 10, 412–419. [Google Scholar] [CrossRef]
- Moosavian, M.; Khoshkholgh, S.M.; Khosravi, N.A.; Montazeri, E.A. Detection of OqxAB Efflflux Pumps, a Multidrug-Resistant Agent in Bacterial Infection in Patients Referring to Teaching Hospitals in Ahvaz, Southwest of Iran. Int. J. Microbiol. 2021, 2021, 2145176. [Google Scholar] [CrossRef] [PubMed]
- Ma, T.; McAllister, T.A.; Guan, L.L. A review of the resistome within the digestive tract of livestock. J. Anim. Sci. Biotechnol. 2021, 12, 121. [Google Scholar] [CrossRef] [PubMed]
- Mlynarczyk Bonikowska, B.; Kowalewski, C.; KrolakU, A.; Marusza, W. Molecular Mechanisms of Drug Resistance in Staphylococcus aureus. Int. J. Mol. Sci. 2022, 23, 8088. [Google Scholar] [CrossRef] [PubMed]
- Banafsheh, D.M.; Hesam, A.; Hossein, S.K.; Afsaneh, K. Antimicrobial categories in describing multidrug resistance, extensive drug resistance and pan-drug resistance in Pseudomonas aeruginosa and Acinetobacter baumannii. Rev. Med. Microbiol. 2020, 32, 6–11. [Google Scholar]
- Arias, C.A.; Murray, B.E. Antibiotic-resistant bugs in the 21st century—A clinical super-challenge. N. Engl. J. Med. 2009, 360, 568–569. [Google Scholar] [CrossRef]
- Zhang, Z.J.; Wu, L.N.; Wang, Y.L.; Zhou, X.Z.; Liu, J.H.; Liu, Y. Mohnarin 2009 annual report: Bacterial resistance surveillance of patients age more than 65 years. Chin. J. Clin. Pharmacol. 2011, 27, 501–507. (In Chinese) [Google Scholar]
- Liu, D.H.; Hu, D.C.; Lu, Z.; Ren, B.J.; Wang, X.; Yin, L.M.; Qian, J.; Qin, H.Y. Analysis of Clinical Distribution and Transition of Drug Resistance of Acinetobacter baumannii in the Year of 2002–2011. Chin. Licens. Pharm. 2015, 1, 8–12. [Google Scholar]
- Chen, K.; Gao, Y.; Li, L.L.; Zhang, W.X.; Li, J.Y.; Zhou, Z.P.; He, H.S.; Chen, Z.L.; Liao, M.; Zhang, J.M. Increased Drug Resistance and Biofilm Formation Ability in ST34-Type Salmonella typhimurium Exhibiting Multicellular Behavior in China. Front. Microbiol. 2022, 13, 876500. [Google Scholar] [CrossRef]
- Cai, L.; Yang, C.; Jia, W.F.; Liu, Y.; Xie, R.; Lei, T.; Yang, Z.H.; He, X.Q.; Tong, R.S.; Gao, H. Endo/Lysosome-Escapable Delivery Depot for Improving BBB Transcytosis and Neuron Targeted Therapy of Alzheimer’s Disease. Adv. Funct. Mater. 2020, 30, 1909999. [Google Scholar] [CrossRef]
- Wiedemeyer, K.; Köbel, M.; Koelkebeck, H.; Xiao, Z.; Vashisht, K. High glypican-3 expression characterizes a distinct subset of ovarian clear cell carcinomas in Canadian patients: An opportunity for targeted therapy. Hum. Pathol. 2020, 98, 56–63. [Google Scholar] [CrossRef]
- Ramachandran, P.; Rachuri, N.K.; Martha, S.; Shakthivel, R.; Gundala, A.; Battu, T.S. Implications of Overprescription of Antibiotics: A Cross-Sectional Study. J. Pharm. Bioallied Sci. 2019, 11, S434–S437. [Google Scholar] [CrossRef]
- Helaly, A.M.N.; El-Attar, A.M.; Khalil, M.; Ghorab, D.S.E.-D.A.; El-Mansoury, A.M. Antibiotic Abuse Induced Histopathological and Neurobehavioral Disorders in Mice. Curr. Drug Saf. 2019, 14, 199–208. [Google Scholar] [CrossRef]
- Zou, W.C. Horizontal Transfer of Drug-Resistant Plasmid RP4 in Different Microbial Aggregates and Its Effect on Ammonia Oxidation. Master’s Thesis, PLA Academy of Military Medical Sciences, Beijing, China, 2016. [Google Scholar]
- Liu, Y.H.; Wu, Y.F.; Wu, J.; Li, X.; Yu, L.L.; Xie, K.; Zhang, M.Y.; Ren, L.L.; Ji, Y.L.; Li, Y.H. Exposure to Veterinary Antibiotics via Food Chain Disrupts Gut Microbiota and Drives Increased Escherichia coli Virulence and Drug Resistance in Young Adults. Pathogens 2022, 11, 1062. [Google Scholar] [CrossRef]
- Wu, C.R.; Huang, L.L.; Huang, J.H.; Zhou, Y.J.; An, X.M.; Song, Y.Y.; Sun, H.Y.; Hao, H.h.; Cheng, G.Y. Research progress on antimicrobial resistance of pig- and chicken-derived Salmonella and Escherichia coli in China. Chin. J. Antibiot. 2021, 46, 509–517. (In Chinese) [Google Scholar]
- Rothia nasimurium. Available online: https://www.ncbi.nlm.nih.gov/nuccore/OP120784.1 (accessed on 2 August 2022).

| Antimicrobial Types | Genes | Primer Sequences (5′→3′) | Annealing Temperature | Product Size/bp |
|---|---|---|---|---|
| β-lactams | bla TEM | F:CAGAAACGCTGGTGAAAGTA R:ACTCCCCGTCGTGTAGATAA | 55 | 719 |
| bla SHV | F:ATGCGTATATTCGCCTGTG R:CCTCATTCAGTTCCGTTTCC | 55 | 502 | |
| bla CTX-M | F:AGTGAAAGCGAACCGAATC R:CTGTCACCAATGCTTTACC | 55 | 365 | |
| mecA | F:GTTGTAGTTGTCGGGTTTGG R:GTTGTAGTTGTCGGGTTTGG | 56 | 336 | |
| TEM | F:AGGAAGAGTATGATTCAACA R:CTCGTCGTTTGGTATGGC | 51 | 535 | |
| Sulfonamides | sul1 | F:CATTGCCTGGTTGCTTCAT F:CATTGCCTGGTTGCTTCAT | 54 | 238 |
| sul2 | F:CATCATTTTCGGCATCGTC R:TCTTGCGGTTTCTTTCAGC | 54 | 793 | |
| sul3 | F:AGATGTGATTGATTTGGGAGC R:TCTTGCGGTTTCTTTCAGC | 54 | 443 | |
| Quinolones | aac(6′)-Ib | F:TTGCGATGCTCTATGAGTGGCTA R:CTCGAATGCCTGGCGTGTTT | 55 | 482 |
| oqxAB | F:GATCAGTCAGTGGGATAGTTT R:TACTCGGCGTTAACTGATTA | 55 | 671 | |
| qnrA | F:TCAGCAAGAGGATTTCTCA R:GGCAGCACTATTACTCCCA | 54 | 627 | |
| gyrA | F:GGTGACGTAATCGGTAAATA R:ACCATGGTGCAATGCCACCA | 53 | 810 | |
| gyrB | F:CTCCTCCCAGACCAAAGACA R:TCACGACCGATACCACAGCC | 59 | 448 | |
| parC | F:GCGAATAAGTTGAGGAAT R:AGCTCGGAATATTTCGAC | 55 | 417 | |
| parE | F:CTGAACTGCTGGCGGAGATG R:GCGGTGGCAGTGCGACGTAA | 59 | 483 | |
| Aminoglycosides | aadB, | F:GAGGAGTTGGACTATGGATT R:CTTCATCGGCATAGTAAAA | 53 | 208 |
| aacC2 | F:GCAATAACGGAGGCAATTCGA R:CTCGATGGCGACCGAGCTTCA | 56 | 697 | |
| aph(3′)-Ia, | F:ATGGGCTCGCGATAATGTC R:CTCACCGAGGCAGTTCCAT | 56 | 600 | |
| aac(6′)/aph(2″) | F:CCAAGAGCAATAAGGGCATA R:CACTATCATAACCACTACCG | 56 | 220 | |
| ant(6)-I | F:ACTGGCTTAATCAATTTGGG R:GCCTTTCCGCCACCTCACCG | 56 | 597 | |
| Tetracyclines | Tet(A) | F:GCTACATCCTGCTTGCCTTC R:CATAGATCGCCGTGAAGAGG | 59.5 | 210 |
| tet(B) | F:TTGGTTAGGGGCAAGTTTTG R:GTAATGGGCCAATAACACCG | 59.5 | 659 | |
| tet(C) | F:CTTGAGAGCCTTCAACCCAG R:ATGGTCGTCATCTACCTGCC | 59.5 | 418 | |
| tetM | F:GTGTGACGAACTTTACCGAA R:GCTTTGTATCTCCAAGAACAC | 52 | 510 | |
| Macrolides | ermB | F:GAAAAGGTACTCAACCAAATA R:AGTAACGGTACTTAAATTGTTTAC | 48 | 636 |
| mefA | F:AACTATCATTAATCACTAGTGC R:TTCTTCTGGTACTAAAAGTGG | 50 | 346 | |
| Lincosamides | LinA | F:GGTGGCTGGGGGGTAGATGTATTAACTGG R:GCTTCTTTTGAAATACATGGTATTTTTCGA | 57 | 323 |
| Chloramphenicols | fexA | F:TTGGGAAGAATGGTTCAGGG R:ATCGGCTCAGTAGCATCACG | 50 | 977 |
| Group | Quantity/pcs | Concentration/(CFU·mL−1) | Dosage/mL | Infection Method | Number of Deaths/pcs | Mortality Rate/% |
|---|---|---|---|---|---|---|
| 1 | 3 | 3 × 105 | 0.2 | orally | 0 | 0 |
| 2 | 3 | 3 × 107 | 0.2 | orally | 0 | 0 |
| 3 | 3 | 3 × 108 | 0.2 | orally | 0 | 0 |
| 4 | 3 | 3 × 105 | 0.2 | injected intraperitoneally | 0 | 0 |
| 5 | 3 | 3 × 107 | 0.2 | injected intraperitoneally | 0 | 0 |
| 6 | 3 | 3 × 108 | 0.2 | injected intraperitoneally | 3 | 100 |
| 7 | 3 | 0.9% normal saline | 0.2 | injected intraperitoneally | 0 | 0 |
| Substrate | Result |
|---|---|
| Maltose | + |
| Sucrose | + |
| Glucose | + |
| Lactose | − |
| Urea | − |
| Mannitol | − |
| Sodium citrate | − |
| Hydrogen sulfide | − |
| Drug Name | Judging Standard | Actual Result | Result | Drug Name | Judging Standard | Actual Result | Result |
|---|---|---|---|---|---|---|---|
| Penicillin | ≥15, ≤14 | 21 | susceptible | Ciprofloxacin | ≥21, ≤15 | 12 | resistant |
| Ceftazidime | ≥18, ≤14 | 0 | resistant | Norfloxacin | ≥17, ≤12 | 0 | resistant |
| Ampicillin/sulbactam | ≥15, ≤11 | 0 | resistant | Erythromycin | ≥23, ≤13 | 0 | resistant |
| Levofloxacin | ≥17, ≤13 | 0 | resistant | Meropenem | ≥20, ≤15 | 13 | resistant |
| Cefoxitin | ≥18, ≤14 | 0 | resistant | Imipenem | ≥23, ≤19 | 17 | resistant |
| Tobramycin | ≥15, ≤12 | 0 | resistant | Azithromycin | ≥13, ≤12 | 0 | resistant |
| Gentamicin | ≥15, ≤12 | 0 | resistant | Chloramphenicol | ≥18, ≤12 | 10 | resistant |
| Amikacin | ≥17, ≤14 | 20 | susceptible | Moxifloxacin | ≥24, ≤20 | 0 | resistant |
| Tetracycline | ≥15, ≤11 | 0 | resistant | Sulfamethoxazole-trimethoprim | ≥16, ≤10 | 0 | resistant |
| Tigecycline | ≥15, ≤13 | 22 | susceptible | Clindamycin | ≥21, ≤14 | 0 | resistant |
| Drug Name | Mic (mg/L) | Actual Result | Drug Name | Mic (mg/L) | Result |
|---|---|---|---|---|---|
| Penicillin | <0.12 | susceptible | Ciprofloxacin | 64 | resistant |
| Ceftazidime | >128 | resistant | Norfloxacin | >16 | resistant |
| Ampicillin/sulbactam | 32/16 | resistant | Erythromycin | >128 | resistant |
| Levofloxacin | >64 | resistant | Meropenem | 128 | resistant |
| Cefoxitin | >32 | resistant | Imipenem | 8 | resistant |
| Tobramycin | >16 | resistant | Azithromycin | >8 | resistant |
| Gentamicin | >16 | resistant | Chloramphenicol | >32 | resistant |
| Amikacin | <16 | susceptible | Moxifloxacin | >8 | resistant |
| Tetracycline | >16 | resistant | Sulfamethoxazole-trimethoprim | >320 | resistant |
| Tigecycline | <0.5 | susceptible | Clindamycin | >128 | resistant |
Publisher’s Note: MDPI stays neutral with regard to jurisdictional claims in published maps and institutional affiliations. |
© 2022 by the authors. Licensee MDPI, Basel, Switzerland. This article is an open access article distributed under the terms and conditions of the Creative Commons Attribution (CC BY) license (https://creativecommons.org/licenses/by/4.0/).
Share and Cite
Zhang, J.; Mo, S.; Li, H.; Yang, R.; Liu, X.; Xing, X.; Hu, Y.; Li, L. Rothia nasimurium as a Cause of Disease: First Isolation from Farmed Chickens. Vet. Sci. 2022, 9, 653. https://doi.org/10.3390/vetsci9120653
Zhang J, Mo S, Li H, Yang R, Liu X, Xing X, Hu Y, Li L. Rothia nasimurium as a Cause of Disease: First Isolation from Farmed Chickens. Veterinary Sciences. 2022; 9(12):653. https://doi.org/10.3390/vetsci9120653
Chicago/Turabian StyleZhang, Jiahao, Shaojiang Mo, Hu Li, Ruizhi Yang, Xiangjie Liu, Xiaoyue Xing, Yahui Hu, and Lianrui Li. 2022. "Rothia nasimurium as a Cause of Disease: First Isolation from Farmed Chickens" Veterinary Sciences 9, no. 12: 653. https://doi.org/10.3390/vetsci9120653
APA StyleZhang, J., Mo, S., Li, H., Yang, R., Liu, X., Xing, X., Hu, Y., & Li, L. (2022). Rothia nasimurium as a Cause of Disease: First Isolation from Farmed Chickens. Veterinary Sciences, 9(12), 653. https://doi.org/10.3390/vetsci9120653

